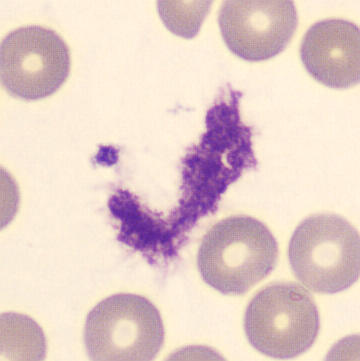
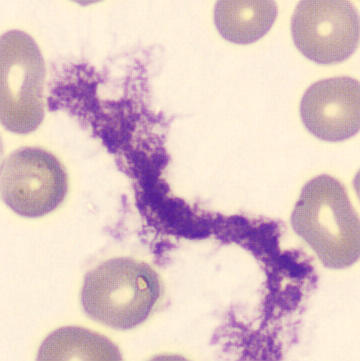
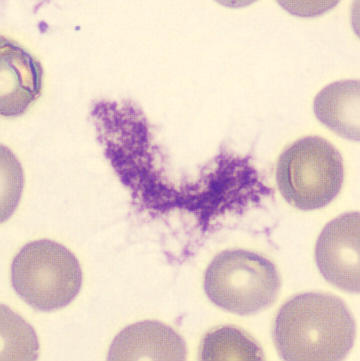

WNR - Interference
FSC
SFL
Leukocytes
Basophils
NRBCs
Debris
Clumps
A prominent population extends from the debris region through the aggregate region to the upper right . This strip consists of particles resistant to the lysis reagent of the WNR channel. Examples include platelet aggregates and contamination with gel, as used in local anesthesia of the puncture site (lidocaine) or in ultrasound-guided venipunctures. In particular, the width and final height of the strip makes platelet aggregates less likely as a cause.
Lidocaine is used particularly in small children or patients with lancing anxiety. Indications for ultrasound-guided puncture are poor venous visibility, such as in edema, obesity, burns, deeper (and larger) veins and sometimes in children.
In the case of gel, an abnormality can usually be seen in the WDF channel as well.
Possible morphology